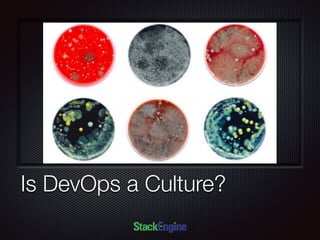
Text
Is DevOps a Culture?

The document discusses the role of Docker in DevOps, emphasizing its significance in creating a culture that automates processes, enhances communication, and fosters innovation. It outlines various aspects of DevOps, including the importance of microservices, process density, and configuration management simplification. Additionally, it highlights the challenges and advantages of adopting Docker, noting that its successful implementation requires a developer-driven approach to system architecture.